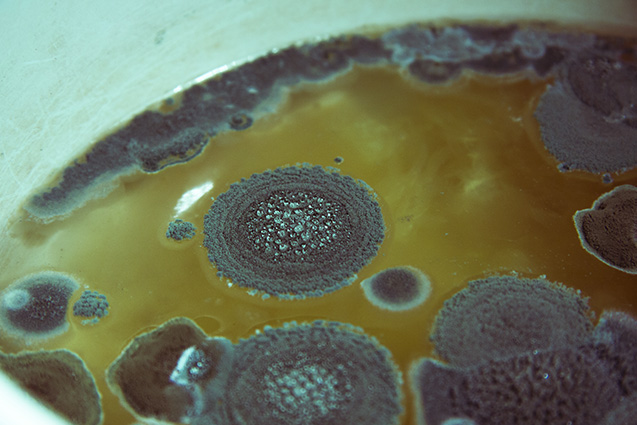

[spb_row element_name=“Row“ wrap_type=“content-width“ parallax_image_height=“content-height“ parallax_image_movement=“fixed“ parallax_image_speed=“0.5″ bg_video_loop=“yes“ parallax_video_height=“window-height“ parallax_video_overlay=“none“ row_overlay_opacity=“0″ row_col_pos=“default“ width=“1/1″ el_position=“first last“] [spb_column col_sm=“12″ padding_horizontal=“0″ width=“1/1″ el_position=“first last“] [spb_boxed_content type=“coloured“ box_link_target=“_self“ padding_vertical=“0″ padding_horizontal=“0″ width=“1/1″ el_position=“first last“]
vyjadrenia dr. Lešťana v časopise Zdravie na tému PLESNE
[/spb_boxed_content] [spb_blank_spacer height=“30px“ width=“1/1″ el_position=“first last“] [spb_toggle element_name=“ALERGIA NA PLESNE – článok Dr. Lešťana“ title=“ALERGIA NA PLESNE – článok Dr. Lešťana“ open=“false“ width=“1/1″ el_position=“first last“]
Alergia na huby (plesne) Sú všade – v ovzduší, v pôde, v obydliach, ale aj v ľudskom organizme… Najlepšie sa im darí tam, kde je vlhko a teplo. Možno ich ani neregistrujete. Až kým vám alebo vášmu dieťaťu nezačnú škodiť… Majú rôzne „podoby“. Ako tmavé škvrny v špárach v sprchovacom kúte, zelená „hmota“ na zabudnutom chlebe, „čudný“ vzduch v dlho nevetranej skrini, „čosi“ žlté na nechtoch po pobyte v plavárni… „Sprevádzajú nás na každom kroku… A hoci u osôb, ktoré majú s týmito prejavmi ťažkosti, hovoríme o alergii na plesne, nie je to správne označenie,“ objasňuje nám alergiológ MUDr. Martin Lešťan z Alergoimunologického centra v Prešove a v Sabinove. „Pravda je taká, že pleseň je iba jedna konkrétna trieda húb. Takže správne by sme mali hovoriť o alergii na huby. Huby sú všadeprítomné, existujú už milióny rokov a sú tak prispôsobené na prežitie aj v extrémnych podmienkach, že by určite prežili aj prípadnú katastrofu našej planéty. Spóry húb sa tvoria v obrovských množstvách a huby ich uvoľňujú do prostredia. Keďže sú veľmi malé, ľahko sa vznášajú, presúvajú vetrom na veľké vzdialenosti. Človek ich ľahko vdýchne, čím sa stávajú výrazným alergénom, ale i patogénom pre naše dýchacie ústrojenstvo.“Hubám pre svoj rast stačí teplota cca 20 – 30 °C, dostatok vody, malé množstvo kyslíka, stopy cukru ap. Niektoré huby dokonca dokážu produkovať spóry, ktoré utlmené prežívajú pri teplotách – 55 až + 60 °C a vlhkosti 0 %. V prírode i domaPodľa výskytu sa huby (ľudovo nazývané plesne) rozdeľujú na vonkajšie a vnútorné (bytové). Ako však upozorňuje alergiológ, toto delenie je len orientačné, pretože vnútorné sa môžu množiť aj vo vonkajšom prostredí, a naopak.Vonkajšie – vrchol ich výskytu býva v lete po daždivých obdobiach. Objavujú sa na listoch, v hline, v pokosenej tráve.V zime vo vlhkom počasí sa môžu ako tmavé škvrny objavovať aj v budovách, napr. na chladných stenách, v okolí okien, v kúpeľniach, pivniciach…Vnútorné – vyžadujú tmu a vlhko, no spóry uvoľňujú i v suchu.Ich výskyt v budovách závisí od toho, v akom stave sú, do akej miery sú vetrané a či je v nich znižovaná vlhkosť.
Niektoré vnútorné plesne sú pre svoje pozitívne účinky využívané napr. pri výrobe sladu, plesňových syrov ap.
RASTER:
Alergiologicky významné huby Dôležité je vedieť, že nie všetky huby spôsobujú alergie. Medzi najčastejšie alergény patria: Alternaria alternata– „obľubuje“ vlhko,jej rezervoárom je hlavne pôda, ale rastie aj na odumretých rastlinách (komposty, hnijúce drevo), darí sa jej vo vtáčích hniezdach, na rôznych potravinách (čierne škvrny na paradajkách…), ba aj v textíliách, vlhkých okenných rámoch. Aspergilus fumigatus– rastieaj v chladnejších podmienkach. Nachádza sa v pôde, v lesnom humuse, v hnijúcich potravinách, v truse zvierat (najmä vtáčom).Candida albicans– kandidy sú bežné v pôde, v akejkoľvek rozkladajúcej sa hmote. Pri oslabenej imunite môžu vyvolávať nepríjemné infekcie u človeka. Cladosporium herbarum – objavujú sa v rozkladajúcom sa lístí, v pôde, v nevetraných bytoch, na potravinách, v neudržiavaných chladničkách, na vlhkých okenných rámoch, v „zatuchnutých“ textíliách.Penicilium notatum – darí sa jej vo vonkajšom aj vnútornom prostredí. Okrem pôdy, tráv rastie aj v našich obydliach, v ovocí, zelenine, orieškoch, ale aj v pečive. AktinomycétyKu hubám sa niekedy nesprávne priradzujú aj tzv. aktinomycéty. Hoci sa v mnohom podobajú na huby, sú to baktérie. „Tiež vytvárajú spóry, ktoré sú ešte menšie ako spóry húb a človek ich môže vdýchnuť do tých najmenších dýchacích ciest. Okrem alergických ochorení, ktoré aktinomycéty často spôsobujú, vedia znepríjemniť život aj svojimi dráždivými, toxickými a infekčnými účinkami.“ Ľahké až ťažké prejavyŠtatistiky uvádzajú, že alergiou na huby (plesne) trpí až 6 % populácie a do 30 % ľudí s atopickým ekzémom, čo nie je malé číslo. „Pre tieto osoby je typická alergická astma a nádcha, ale huby spôsobujú aj nepríjemné ochorenia dýchacích ciest, akými je tzv. alergická bronchopulmonálna mykóza a hypersenzitívna pneumonitída (zápal pľúc). Respiračnú alergiu spôsobuje minimálne 80 druhov húb. Veľa húb sa uplatňuje pri rôznych kožných infekciách (mykózy…). Mnohé huby produkujú nebezpečné toxíny, niektoré z nich môžu mať aj rakovinotvorné účinky (toxín v pokazených orieškoch…). Aj preto platí stará dobrá zásada, ak sa objaví na potravine pleseň (a je jedno či je to čerstvé ovocie alebo konzervovaný výrobok, napr. lekvár) – je nutné celú potravinu vyhodiť, nestačí odstrániť iba splesnenú vrstvu,“ upozorňuje MUDr. Lešťan.Niektorí ľudia ani netušia, že niektoré druhy húb sa uplatňujú aj ako tzv. „profesijné alergény“. O čo ide? „Pri ich pravidelnom a dlhodobom vdychovaní môžu vyvolávať profesijnú alergickú nádchu, astmu, ochorenia kože, ale aj hypersenzitívny zápal pľúc, čo sú už vážne diagnózy.“ RASTERHlavné príznaky alergie na huby (plesne): · kýchanie· opuch sliznice nosovej dutiny· pocit plného nosa· alergická nádcha· zapálené, začervenané oči· ťažkosti s dýchaním· kašeľ· únava· svrbenie kože, ekzém· bolesti hlavy atď. Diagnostika je náročnáStanoviť túto alergiu nie je ľahké, je pomerne zložitá a patrí do rúk špecialistu. Pri prvom kontakte lekára zaujíma anamnéza pacienta s dôrazom na okolnosti vzniku ťažkostí (kedy, za akých podmienok sa objavuje alergická nádcha, kašeľ ap.), u dospelých je dôležitá pracovná anamnéza, u malých i veľkých pacientov ich bytové podmienky, vlhkosť budov ap.„Po dôslednej anamnéze a fyzikálnom vyšetrení sa alergiológ snaží otestovať možnú alergiu na huby kožnými testami, ale aj vyšetreniami špeciálnych IgE protilátok z krvi,“ objasňuje MUDr. Lešťan a pokračuje: „Vzhľadom na veľkú variabilitu húb je niekedy diagnostika náročná a zdĺhavá. Napriek výrazným sezónnym výkyvom v množstve spór v ovzduší má väčšina pacientov precitlivených na huby celoročné symptómy, pretože hlavne alergiologicky významné huby sa množia aj v bytoch a rodinných domoch, najmä ak sú vlhké, prípadne je v nich veľa kvetov, či organický odpad…“
Možno túto alergiu (vy)liečiť?Ako upozorňuje MUDr. Lešťan, „pre alergikov je dôležité nielen dodržiavanie „protiplesňových opatrení“, ale aj pravidelné užívanie liekov, pravidelné dispenzárne kontroly u alergiológa, ktorý sa za pomoci pacienta snaží dostať ochorenie pod kontrolu a zamedziť progresii alergického ochorenia (t.j. aby napr. alergická nádchy prešla do astmy ap.).“ K liečbe alergie na huby (plesne) sa ordinujú pacientom inhalačné spreje s kortikosteroidmi, ktoré liečia alergický zápal. Významné sú aj antihistaminové lieky a antileukotriény, ktoré blokujú histamín a leukotriény, vznikajúce pri alergickej reakcii. Vo vážnejších prípadoch musí pacient postupovaťimunoterapiu vakcínami.Je možné túto alergiu ÚPLNE vyliečiť, alebo sa iba tlmia symptómy? Stáva sa, že sa u detí vekom „stráca“? 2 vety „TU býva ALERGIK“V domácnosti každého alergika je nutné dodržiavať určité režimové opatrenia. Ani pri alergii na huby (plesne) nie je v tomto smere výnimka. Odporúča sa:
- odstrániť všetky viditeľné plesne
- pravidelne kontrolovať (najmä v zimných mesiacoch) rámy okien, staršie tapety, dlho neotvárané skrine…
- kúpeľňu, WC pravidelne čistiť, vetrať a udržiavať v suchu
- často vetrať, avšak nie keď vonku prší, sneží
- kúpiť si vlhkomer a udržiavať vlhkosť v miestnosti pod 50 %
- používať odvlhčovače
- nepoužívať zvlhčovače, osviežovače vzduchu
- nesušiť vo vnútri bielizeň
- nefajčiť v miestnostiach
- nenechávať v domácnosti neuskladnené zvyšky potravín
- smetné koše vynášať každý deň
- zvážiť v domácnosti izbové kvety, akváriá, klimatizačné zariadenia
- ak sa v kvetináčoch objaví na hline biely povlak, odstrániť ho
- pozor na staré domy, nevetrané pivnice, v ktorých cítiť „zatuchnutý“ vzduch
- pozor na neodborné zatepľovania starších budov, výmenu okien,…)
- nekonzumovať potraviny napadnuté plesňou
- nekonzumovať plesňové syry
RASTERPri pobyte V PRÍRODE platí: * neprechádzať sa, keď prší, je príliš vlhko, hmla;* vyhýbať sa prechádzkam v okolí vodných plôch;* po návrate z prírody si prepláchnuť nos slanou vodou;* deti by sa nemali hrať (dospelí pracovať) s lístím, slamou, senom ap. – Alergia na plesne najviac trápi v lete a v jeseni. No v nevetraných a zle udržiavaných domácnostiach môže byť problémom počas celého roka. SPRACOVALA: PaedDr. Dagmar Baluchová
[/spb_toggle] [spb_toggle element_name=“Prečo vyhľadať práve nás?“ title=“Prečo vyhľadať práve nás?“ open=“false“ width=“1/1″ el_position=“first last“]
- tím 3 atestovaných imunoalergológov s mnohoročnou praxou a nutričného špecialistu – absoloventa LF Masarykovej univerzity
- medzinárodné skúsenosti v odbore alergií, astmy, kožných prejavov alergií, potravinových alergií a intolerancií (Rakúsko, Anglicko, Česká republika )
- naši lekári publikujú a prednášajú na témy alergických a imunologických ochorení ( kongresy, množstvo článkov pre verejnosť a edukačných materiálov,…)
- Držíme tempo s medzinárodnou úrovňou ( medzi prvými pracoviskami v SR sme zaviedli do diagnostiky potravinové patch testy, komponentovú diagnostiku, záťažové potravinové testy, edukčné programz pre alergikov ,….)
[/spb_toggle] [/spb_column] [/spb_row]